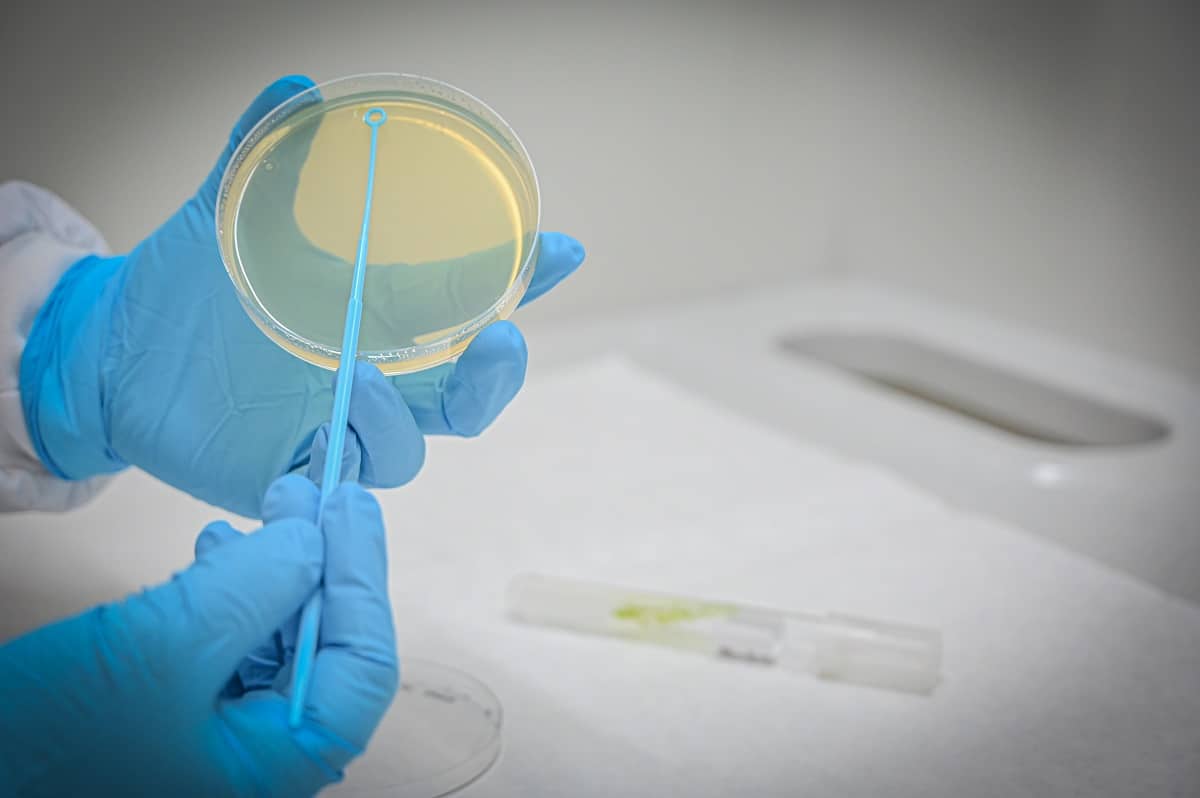

Suscríbete a nuestra newsletter

La Comisión Europea está trabajando en el desarrollo de la futura Ley Europea de Biotecnología para impulsar la competitividad, sostenibilidad y seguridad económica de la UE mediante el desarrollo y comercialización de productos biotecnológicos. Esta iniciativa, prevista para el tercer trimestre de 2026, se enmarca en una estrategia más amplia para las ciencias de la vida y responde a la necesidad de transformar el potencial científico europeo en productos y servicios comercializables.

José María Ferrer Villar
Desde que me incorporé a AINIA en 1997, he trabajado en el ámbito del Derecho Alimentario. Por mi formación en Derecho y mi especialización en el ámbito agroalimentario he podido abordar actividades asociadas con la consultoría y con la docencia a través la participación en proyectos multidisciplinares en colaboración con empresas de distintos sectores agroalimentarios. Me motiva especialmente aplicar el conocimiento técnico a retos reales del mercado, facilitando la interpretación y aplicación del Derecho Alimentario por parte de los operadores.


| Responsable | AINIA |
| Domicilio | Calle Benjamín Franklin, 5 a 11, CP 46980 Paterna (Valencia) |
| Finalidad | Atender, registrar y contactarle para resolver la solicitud que nos realice mediante este formulario de contacto |
| Legitimación | Sus datos serán tratados solo con su consentimiento, al marcar la casilla mostrada en este formulario |
| Destinatarios | Sus datos no serán cedidos a terceros |
| Derechos | Tiene derecho a solicitarnos acceder a sus datos, corregirlos o eliminarlos, también puede solicitarnos limitar su tratamiento, oponerse a ello y a la portabilidad de sus datos, dirigiéndose a nuestra dirección postal o a privacy@ainia.es |
| Más info | Dispone de más información en nuestra Política de Privacidad |
| DPD | Si tiene dudas sobre como trataremos sus datos o quiere trasladar alguna sugerencia o queja, contacte al Delegado de protección de datos en info@businessadapter.es o en el Formulario de atención al interesado |
Consiento el uso de mis datos personales para que atiendan mi solicitud, según lo establecido en su Política de Privacidad
Consiento el uso de mis datos para recibir información y comunicaciones comerciales de su entidad.
